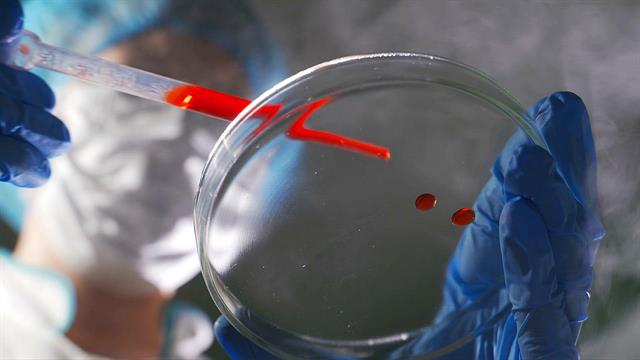
Ιός Epstein-Barr: Ποιοι είναι οι κίνδυνοι όταν ξυπνήσει

Ο ιός Epstein-Barr δεν προκαλεί ασθένειες βραχυπρόθεσμα, αλλά μακροπρόθεσμα μιας και ο ιός παραμένει στον οργανισμό για μια ζωή μετά την αρχική μόλυνση και επανενεργοποιείται κατά καιρούς, και μπορεί να έχει σημαντικές συνέπειες που παραπέμπουν σε αυτοάνοσα νοσήματα και καρκίνο μέχρι σοβαρό φλεγμονώδες σοκ PIMS.
Είναι ο πρώτος ιός που συνδέεται με την ανάπτυξη καρκίνου. Ο ιός Epstein-Barr (EBV), ένας ιός DNA της οικογένειας των ερπητοϊών, είναι επίσης γνωστός ως ανθρώπινος ερπητοϊός 4 (HHV4).
Ανακαλύφθηκε το 1964 από τους Βρετανούς ιολόγους Anthony Epstein και Yvonne Barr - στα εκφυλισμένα Β κύτταρα ενός ασθενούς με λέμφωμα Burkitt.
Από τότε είναι γνωστό ότι ο EBV μπορεί να εμπλέκεται στην ανάπτυξη καρκίνου.
Σήμερα γνωρίζουμε ότι ο ιός δεν παίζει ρόλο μόνο στο λέμφωμα Burkitt, αλλά και σε άλλες μορφές καρκίνου, όπως το λέμφωμα Hodgkin, το σπάνιο ρινοφαρυγγικό καρκίνωμα που εμφανίζεται κυρίως στη Νοτιοανατολική Ασία, διάφορα γαστρικά καρκινώματα και τα λεμφώματα μετά από μεταμόσχευση (PTLD).
Το παθογόνο σχετίζεται επίσης με αυτοάνοσα νοσήματα: Η λοίμωξη με τον EBV συνδέεται επιδημιολογικά με τον συστηματικό ερυθηματώδη λύκο, το σύνδρομο Sjögren και τη ρευματοειδή αρθρίτιδα, καθώς και με άλλα αυτοάνοσα νοσήματα, συμπεριλαμβανομένης της σκλήρυνσης κατά πλάκας. Πώς μπορεί ο ιός να προκαλέσει τόσες πολλές βλάβες στο σώμα;
Ο ιός Epstein-Barr προκαλεί δια βίου λοίμωξη
Ο ιός DNA βρίσκεται σχεδόν παντού. Έως και το 99% των ανθρώπων παγκοσμίως μολύνονται από τον EBV κατά τη διάρκεια της ζωής τους. Μια αρχική λοίμωξη στην παιδική ηλικία παραμένει συνήθως ασυμπτωματική - στους εφήβους και τους νεαρούς ενήλικες μπορεί να προκαλέσει λοιμώδη μονοπυρήνωση (αδενικός πυρετός Pfeiffer) με συμπτώματα όπως πυρετός, διόγκωση των λεμφαδένων και αμυγδαλίτιδα.
Μόλις το παθογόνο βρεθεί στον οργανισμό, πολλαπλασιάζεται για λίγο και στη συνέχεια φωλιάζει σε ειδικά κύτταρα του ανοσοποιητικού συστήματος, όπως τα κύτταρα μνήμης Β, καθώς και σε επιθηλιακά κύτταρα, όπου παραμένει σε λανθάνουσα κατάσταση. Παραμένει μάλιστα εκεί για όλη του τη ζωή.
Στη φάση λανθάνουσας κατάστασης, ο ιός εκφράζει μόνο λίγες πρωτεΐνες από τα λεγόμενα λανθάνουσα γονίδια- το γονιδίωμα είναι στενά συσκευασμένο, σε μεγάλο βαθμό ανενεργό και προσκολλημένο στη χρωματίνη του κυττάρου ξενιστή.
Σε ορισμένες περιπτώσεις, ιδίως στην περίπτωση εξασθενημένου ή λανθασμένα προσανατολισμένου ανοσοποιητικού συστήματος, ο ιός EB μπορεί να επανενεργοποιηθεί: Τότε εκφράζονται άλλα ιικά γονίδια (λυτικά γονίδια). Ο ιός πολλαπλασιάζεται, καταστρέφει τα κύτταρα του ξενιστή και μολύνει άλλα. Η μόλυνση και η επανενεργοποίηση του EBV φαίνεται να παίζουν ρόλο στην παθογένεια των αυτοάνοσων νοσημάτων.
Η σκλήρυνση κατά πλάκας ως όψιμη επιπλοκή της λοίμωξης από EBV
Ένα εξέχον παράδειγμα είναι η σκλήρυνση κατά πλάκας (ΣΚΠ). Η σχέση μεταξύ της λοίμωξης από EBV και αυτής της συχνής χρόνιας φλεγμονώδους νόσου του κεντρικού νευρικού συστήματος παρουσιάστηκε από τον καθηγητή Dr. Klemens Ruprecht από το Τμήμα Νευρολογίας του νοσοκομείου Charité του Βερολίνου στο συνέδριο της Γερμανικής Νευρολογικής Εταιρείας στο Βερολίνο στα τέλη του 2024.
Σε μελέτες, αντισώματα κατά του EBV βρέθηκαν στο 100% των ασθενών με σκλήρυνση κατά πλάκας. Επιπλέον, οι ασθενείς με σκλήρυνση κατά πλάκας είχαν υψηλότερους τίτλους αντισωμάτων κατά του EBV σε σχέση με τα άτομα χωρίς τη νόσο.
Η λοιμώδης μονοπυρήνωση διπλασιάζει τον κίνδυνο εμφάνισης ΣΚΠ, ανέφερε ο γιατρός.
Αν συνοψίσουμε όλα τα δεδομένα, προκύπτει μια σαφής εικόνα. "Η σκλήρυνση κατά πλάκας είναι μια σπάνια όψιμη επιπλοκή της λοίμωξης από τον ιό Epstein-Barr", δήλωσε ο Ruprecht. "Τα δεδομένα είναι συντριπτικά".
Η λοίμωξη από τον EBV δεν αρκεί από μόνη της για να πυροδοτήσει την παθογένεια. Πρέπει να εμπλέκονται και άλλοι παράγοντες, όπως η γενετική προδιάθεση, οι περιβαλλοντικοί ρύποι ή οι παράγοντες του τρόπου ζωής.
Οι μηχανισμοί με τους οποίους ο ιός πυροδοτεί την αυτοανοσία δεν είναι ακόμη κατανοητοί, δήλωσε ο γιατρός. Συζητούνται διάφοροι μηχανισμοί. Ένας από αυτούς είναι ο λεγόμενος μοριακός μιμητισμός, κατά τον οποίο τα αντισώματα και τα Τ-κύτταρα που στρέφονται κατά του EBV αναγνωρίζουν και επιτίθενται επίσης σε αντιγόνα του ΚΝΣ λόγω δομικών ομοιοτήτων.
Η υπόθεση αυτή συζητείται εδώ και πολύ καιρό, αλλά είναι προβληματική επειδή δεν υπάρχει κλασικό αντιγόνο της σκλήρυνσης κατά πλάκας και επειδή τα αντισώματα του EBV βρίσκονται πολύ σπάνια στο ΚΝΣ.
Επιπλέον, συζητείται επίσης μια άμεση μόλυνση του εγκεφάλου με τον EBV, η ανάπτυξη αυτοδραστικών Β λεμφοκυττάρων και μια απορρυθμισμένη ανοσολογική απάντηση έναντι του παθογόνου. Σύμφωνα με τον ομιλητή, κανένας από αυτούς τους μηχανισμούς δεν είναι πολύ πειστικός.
Κατά τη γνώμη του, τα Β κύτταρα παίζουν κεντρικό ρόλο στην παθογένεια, καθώς οι ιοί μολύνουν και επαναπρογραμματίζουν τα κύτταρα αυτά και η εξάντληση των Β κυττάρων είναι θεραπευτικά αποτελεσματική.
Το 2016, ο Ruprecht και οι συνεργάτες του υπέθεσαν ότι σε μεταγενέστερους ασθενείς με πολλαπλή σκλήρυνση, ο ιός προκαλεί τη μετανάστευση των Β κυττάρων που παράγουν αντισώματα στον εγκέφαλο κατά τη στιγμή της οξείας λοίμωξης από τον EBV ("Medical Hypotheses"). Αυτό θα μπορούσε να εξηγήσει γιατί οι ασθενείς με σκλήρυνση κατά πλάκας εμφανίζουν συχνά παραγωγή αντισωμάτων κατά της ιλαράς, της ερυθράς και του έρπητα ζωστήρα στον εγκέφαλο, αλλά πολύ σπάνια κατά του EBV.
Αυτό οφείλεται στο γεγονός ότι δεν υπάρχουν Β κύτταρα που κατευθύνονται κατά του EBV κατά τη στιγμή της οξείας λοίμωξης. Το πώς ακριβώς ο ιός Epstein-Barr επάγει τα Β κύτταρα να μεταναστεύσουν στον εγκέφαλο είναι ακόμη ασαφές.
Διαταραχές του ανοσοποιητικού που σχετίζονται με τον EBV
Οι μηχανισμοί με τους οποίους ο EBV μπορεί να προάγει την αυτοανοσία πέραν της σκλήρυνσης κατά πλάκας περιγράφηκαν από τον καθηγητή Dr. William H. Robinson και τους συνεργάτες του από το Πανεπιστήμιο του Στάνφορντ σε ένα άρθρο ανασκόπησης στην επιθεώρηση "Nature Reviews Rheumatology" το 2024.
Σύμφωνα με το άρθρο, υπάρχουν διάφοροι, όχι αμοιβαία αποκλειόμενοι μηχανισμοί με τους οποίους ο EBV θα μπορούσε να αυξήσει την αυτοανοσία, συμπεριλαμβανομένου του επαναπρογραμματισμού των Β κυττάρων, της ανοσολογικής αποφυγής ή της λυτικής επανενεργοποίησης του ιού.
Η επανενεργοποίηση του EBV φαίνεται να σχετίζεται με την εμφάνιση ή την έξαρση αυτοάνοσων νοσημάτων. Υπάρχουν σχετικές ενδείξεις για παράδειγμα για τον συστηματικό ερυθηματώδη λύκο, τη ρευματοειδή αρθρίτιδα και το σύνδρομο Sjögren.
Ο επηρεασμός του ανοσοποιητικού συστήματος θα μπορούσε να διαδραματίσει κάποιο ρόλο: Για παράδειγμα, αρκετά γονιδιακά προϊόντα του EBV της λανθάνουσας και της λυτικής φάσης αναστέλλουν τις έμφυτες ή προσαρμοστικές ανοσολογικές αποκρίσεις του ξενιστή.
Έχει αποδειχθεί ότι ο EBV καταστέλλει την έκφραση και τη λειτουργία αντιιικών αγγελιοφόρων που επάγονται από υποδοχείς τύπου Toll και άλλες οδούς του έμφυτου ανοσοποιητικού συστήματος.
Επιπλέον, ο ιός επαναπρογραμματίζει τα κύτταρα Β, αναφέρουν οι συγγραφείς. Ο EBV μολύνει τα αφελή Β κύτταρα, τα οποία μετατρέπονται σε ενεργούς, πολλαπλασιαζόμενους λεμφοβλάστες που εισβάλλουν και εξαπλώνονται στα βλαστικά κέντρα. Ωστόσο, τα μολυσμένα Β κύτταρα μπορούν επίσης να εισέλθουν στο σύστημα του αίματος ως αδρανή κύτταρα μνήμης Β, όπου ο ιός παραμένει σε λανθάνουσα κατάσταση.
Ο EBV ελέγχει τα Β κύτταρα μέσω των λανθάνουσας κατάστασης γονιδίων του τα καθιστά αθάνατα προκειμένου να παραμείνουν όσο το δυνατόν καλύτερα.
Αυτό όχι μόνο διαταράσσει την ανοσολογική απόκριση του ξενιστή, αλλά προάγει και την ανάπτυξη καρκίνου. Τα μολυσμένα λεμφοκύτταρα, αλλά και τα επιθηλιακά κύτταρα που έχουν μολυνθεί από τον EBV, συνδέονται με διάφορους τύπους καρκίνου.
Οι μηχανισμοί που οδηγούν στην αυτοανοσία θα μπορούσαν να είναι παρόμοιοι με εκείνους που συμβάλλουν στην ανάπτυξη του καρκίνου, θεωρούν οι συγγραφείς.
Πώς ο ιός προωθεί την καρκινογένεση
Εκτός από τη μόλυνση από τον EBV, άλλοι παράγοντες, όπως η γενετική σύσταση και εξωτερικοί παράγοντες, πρέπει επίσης να συμβάλλουν στην ανάπτυξη του καρκίνου. Διάφοροι μηχανισμοί που συμβάλλουν στην ογκογένεση είναι πλέον γνωστοί. Για παράδειγμα, ο ιός μπορεί να ματαιώσει αποτελεσματικά τις έμφυτες και προσαρμοστικές ανοσολογικές αποκρίσεις, να αναστείλει την απόπτωση και να προωθήσει τον κυτταρικό πολλαπλασιασμό και την αγγειογένεση.
Οι ιικές ογκοπρωτεΐνες, όπως η LMP1 (λανθάνουσα μεμβρανική πρωτεΐνη 1) και η LMP2A, οι οποίες ενεργοποιούν σημαντικά κυτταρικά μονοπάτια σηματοδότησης, όπως ο NF-κΒ, ρυθμίζουν τους αυξητικούς παράγοντες και έτσι προάγουν την κυτταρική ανάπτυξη, διαδραματίζουν κεντρικό ρόλο σε αυτή τη διαδικασία.
Επιπλέον, η ιική πρωτεΐνη BNRF1 διαταράσσει το σχηματισμό των ατρακτοειδών πόλων κατά τη διάρκεια της κυτταρικής διαίρεσης και, συνεπώς, την κατανομή των χρωμοσωμάτων - που αποτελεί μια άλλη αιτία καρκίνου. Μακροπρόθεσμα, αυτός ο συνδυασμός αυξημένου κυτταρικού πολλαπλασιασμού, αποφυγής του ανοσοποιητικού συστήματος και γενετικής αστάθειας οδηγεί σε συσσώρευση μεταλλάξεων και ανάπτυξη καρκίνου.
Οι Γερμανοί ερευνητές μπόρεσαν επίσης να δείξουν ότι ο καρκίνος μετά από μόλυνση με EBV εξαρτάται επίσης από το στέλεχος του ιού: Διαφορετικά στελέχη του ιού έχουν διαφορετικές ιδιότητες και μπορούν να οδηγήσουν σε διαφορετικές ασθένειες ("Cell Reports").
Προσθέστε το iatronet.gr στο DiscoverΕιδήσεις υγείας σήμερα
Οικογένεια: Το κρίσιμο μέτρο που έχει μείνει στο...ράφι
Φάρμακο: Καθυστερήσεις και εμπόδια στην πρόσβαση των ασθενών
Mέσος όρος 69% το νοσοκομειακό clawback
Ο μηχανισμός που προστατεύει τα κύτταρα από τον θάνατο
Ο μηχανισμός που προστατεύει τα κύτταρα από τον θάνατο Πώς πολλαπλασιάζεται ο ιός της γρίπης παρακάμπτοντας το ανοσοποιητικό
Πώς πολλαπλασιάζεται ο ιός της γρίπης παρακάμπτοντας το ανοσοποιητικό RSV: Ο "αθόρυβος" ιός που απειλεί τους ηλικιωμένους - Το νέο εμβόλιο που μειώνει τις νοσηλείες
RSV: Ο "αθόρυβος" ιός που απειλεί τους ηλικιωμένους - Το νέο εμβόλιο που μειώνει τις νοσηλείες Ανακαλύφθηκαν αντιιικές ουσίες με ευρύ φάσμα δράσης
Ανακαλύφθηκαν αντιιικές ουσίες με ευρύ φάσμα δράσης Πιο διαδεδομένος απ΄ότι φαινόταν ο ιός Oropouche
Πιο διαδεδομένος απ΄ότι φαινόταν ο ιός Oropouche Ιός συρρικνώνει τον καρκίνο του δέρματος πριν από τη χειρουργική αφαίρεση
Ιός συρρικνώνει τον καρκίνο του δέρματος πριν από τη χειρουργική αφαίρεση Φάρμακο: Καθυστερήσεις και εμπόδια στην πρόσβαση των ασθενών
Φάρμακο: Καθυστερήσεις και εμπόδια στην πρόσβαση των ασθενών Οικογένεια: Το κρίσιμο μέτρο που έχει μείνει στο...ράφι
Οικογένεια: Το κρίσιμο μέτρο που έχει μείνει στο...ράφι Μπορούν τρόφιμα να ενισχύσουν την απορρόφηση της βιταμίνης D;
Μπορούν τρόφιμα να ενισχύσουν την απορρόφηση της βιταμίνης D; Ημέρα του Πατέρα: Διατροφικές επιλογές για καλύτερη υγεία
Ημέρα του Πατέρα: Διατροφικές επιλογές για καλύτερη υγεία Ρύζι, πατάτες και ζυμαρικά: Ποιο είναι χειρότερο για το σάκχαρο;
Ρύζι, πατάτες και ζυμαρικά: Ποιο είναι χειρότερο για το σάκχαρο; Με ποιες τροφές να συνδυάζω ρύζι, πατάτες και ζυμαρικά για να μην αυξάνεται απότομα το σάκχαρο
Με ποιες τροφές να συνδυάζω ρύζι, πατάτες και ζυμαρικά για να μην αυξάνεται απότομα το σάκχαρο Pharmathen: Βαθιά κρίση και μηδενισμός αποτίμησης από funds της Partners
Pharmathen: Βαθιά κρίση και μηδενισμός αποτίμησης από funds της Partners Καρπούζι: Ποια είναι τα οφέλη του στην υγεία
Καρπούζι: Ποια είναι τα οφέλη του στην υγεία Ιατρικός Σύλλογος Θεσσαλονίκης: Σαρωτική επικράτηση της ΕΝΟ.ΣΥ. - Ν.Ι.Κ.Ι.
Ιατρικός Σύλλογος Θεσσαλονίκης: Σαρωτική επικράτηση της ΕΝΟ.ΣΥ. - Ν.Ι.Κ.Ι. Φαρμακοβιομηχανίες σκέφτονται να χτυπήσουν την πόρτα της Εθνικής Αρχής Διαφάνειας
Φαρμακοβιομηχανίες σκέφτονται να χτυπήσουν την πόρτα της Εθνικής Αρχής Διαφάνειας Οι απρόσμενες συνέπειες της ολοκληρωτικής παράλειψης της ζάχαρης από τη διατροφή [μελέτη]
Οι απρόσμενες συνέπειες της ολοκληρωτικής παράλειψης της ζάχαρης από τη διατροφή [μελέτη] 9 εξακριβωμένα οφέλη του κολοκυθόσπορου
9 εξακριβωμένα οφέλη του κολοκυθόσπορου